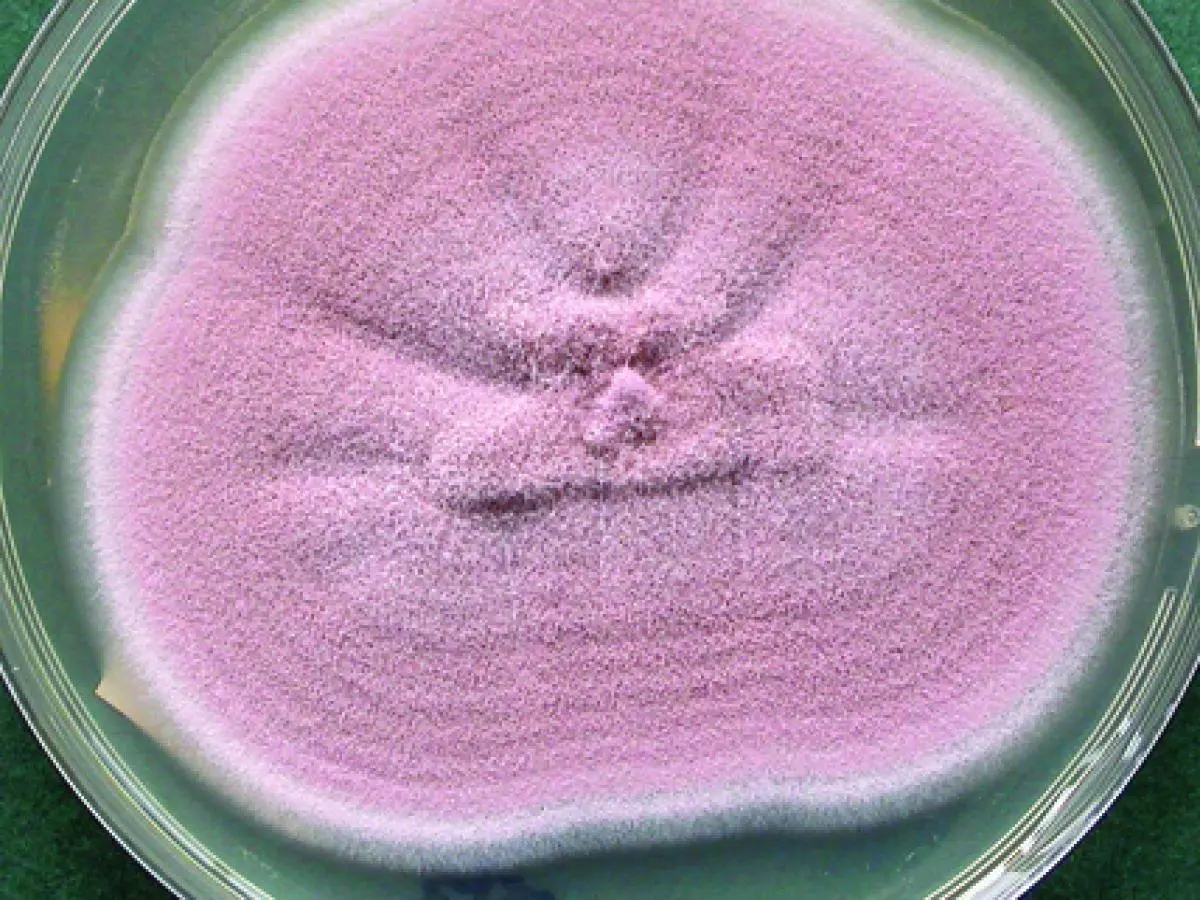
purpureocillium cultivo

BENEFICIOS EN AGRICULTURA
Purpureocillium lilacinum actúa en la parte aérea del cultivo, favoreciendo la adhesión y penetración en hojas y tallos, y estimulando la producción de metabolitos que activan las defensas naturales de la planta
¿Por qué están incorporando este hongo los agricultores más exigentes?
Porque funciona.
Microorganismo efectivo contra araña roja y plagas sin exoesqueleto endurecido.
No deja residuos, ideal para producciones certificadas y cosechas cercanas.
Aplicación foliar sencilla, mediante mojado directo o en tanque
Complementario a estrategias de control biológico, sin afectar a enemigos naturales.
Reducción de tratamientos químicos, mejorando la sostenibilidad y salud del cultivo.
Reduce la presión de plagas sin sacrificar ni un gramo de producción.
¿Qué plagas previene?
Actúa donde otros fallan: sobre estructuras blandas y difíciles de alcanzar.

Araña roja
(Tetranychus urticae)
- Elimina huevos y ninfas por colonización fúngica directa.
- Paraliza la expansión de focos activos.
- Evita la reinfestación y reduce la carga de tratamientos químicos.
Es, sin duda, uno de los mejores hongos agrícolas contra la araña roja.

Vasates del tomate
(Aculops lycopersici)
- Su tamaño microscópico y cuerpo blando los hace extremadamente sensibles.
- Reduce deformaciones foliares y frena el avance del plateado en cultivos sensibles.

Huevos de mosca blanca y trips
(Bemisia tabaci)
- Interfiere en la viabilidad de huevos y larvas inmaduras, dificultando el inicio de infestaciones.

Nematodos fitoparásitos
Phylum Nematoda
- Accede a juveniles y huevos en tejidos colonizados o estructuras aéreas dañadas.
* En formulaciones registradas
¿Por qué comprar un Purpureocillium lilacinum registrado?
Porque el nombre no lo es todo. Lo importante es la cepa, la concentración y el respaldo técnico.
Comprar un producto registrado con cepas autorizadas por el Ministerio de Agricultura garantiza:
- Cepa seleccionada por su eficacia biológica documentada.
- Concentración estandarizada (≥10⁸ UFC/ml o g) para resultados reproducibles.
- Ensayos agronómicos oficiales que avalan su comportamiento en campo.
- Seguridad comprobada para el aplicador y el consumidor final.
- Viabilidad real del hongo hasta el momento de aplicación.
Si quieres aplicar Purpureocillium lilacinum como una herramienta eficaz en tu finca, exige un producto registrado para uso agrícola.